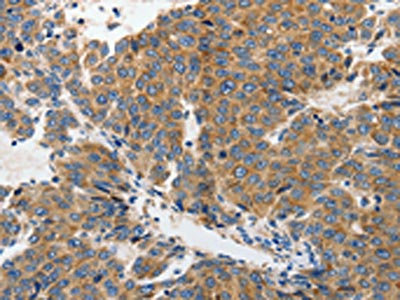

-
中文名稱:GRIA2兔多克隆抗體
-
貨號:CSB-PA788203
-
規格:¥1100
-
圖片:
-
The image on the left is immunohistochemistry of paraffin-embedded Human liver cancer tissue using CSB-PA788203(GRIA2 Antibody) at dilution 1/70, on the right is treated with synthetic peptide. (Original magnification: ×200)
-
The image on the left is immunohistochemistry of paraffin-embedded Human colon cancer tissue using CSB-PA788203(GRIA2 Antibody) at dilution 1/70, on the right is treated with synthetic peptide. (Original magnification: ×200)
-
-
其他:
產品詳情
-
Uniprot No.:
-
基因名:
-
別名:AMPA 2 antibody; AMPA selective glutamate receptor 2 antibody; AMPA-selective glutamate receptor 2 antibody; AMPA2 antibody; GluA2 antibody; GLUR 2 antibody; GLUR B antibody; GluR K2 antibody; GluR-2 antibody; GluR-B antibody; GluR-K2 antibody; GLUR2 antibody; GLURB antibody; Glutamate receptor 2 antibody; Glutamate receptor ionotropic AMPA 2 antibody; Glutamate receptor ionotropic antibody; Gria2 antibody; GRIA2_HUMAN antibody; HBGR2 antibody
-
宿主:Rabbit
-
反應種屬:Human,Mouse,Rat
-
免疫原:Synthetic peptide of Human GRIA2
-
免疫原種屬:Homo sapiens (Human)
-
標記方式:Non-conjugated
-
抗體亞型:IgG
-
純化方式:Antigen affinity purification
-
濃度:It differs from different batches. Please contact us to confirm it.
-
保存緩沖液:-20°C, pH7.4 PBS, 0.05% NaN3, 40% Glycerol
-
產品提供形式:Liquid
-
應用范圍:ELISA,IHC
-
推薦稀釋比:
Application Recommended Dilution ELISA 1:2000-1:10000 IHC 1:100-1:300 -
Protocols:
-
儲存條件:Upon receipt, store at -20°C or -80°C. Avoid repeated freeze.
-
貨期:Basically, we can dispatch the products out in 1-3 working days after receiving your orders. Delivery time maybe differs from different purchasing way or location, please kindly consult your local distributors for specific delivery time.
-
用途:For Research Use Only. Not for use in diagnostic or therapeutic procedures.
相關產品
靶點詳情
-
功能:Receptor for glutamate that functions as ligand-gated ion channel in the central nervous system. It plays an important role in excitatory synaptic transmission. L-glutamate acts as an excitatory neurotransmitter at many synapses in the central nervous system. Binding of the excitatory neurotransmitter L-glutamate induces a conformation change, leading to the opening of the cation channel, and thereby converts the chemical signal to an electrical impulse. The receptor then desensitizes rapidly and enters a transient inactive state, characterized by the presence of bound agonist. In the presence of CACNG4 or CACNG7 or CACNG8, shows resensitization which is characterized by a delayed accumulation of current flux upon continued application of glutamate. Through complex formation with NSG1, GRIP1 and STX12 controls the intracellular fate of AMPAR and the endosomal sorting of the GRIA2 subunit toward recycling and membrane targeting.
-
基因功能參考文獻:
- This review showed that the mutation GR1A protein associate with Obsessive-compulsive disorder. PMID: 28608743
- Measured the expression of GRIA2 and GABRA1 in patients with methamphetamine-use disorder. Also examined whether miR-181a down-regulates GRIA2 and GABRA1 in a cell-based assay. We further examined the effects of chronic methamphetamine exposure on the expression of miR-181a, GRIA2 and GABRA1. The results demonstrated that serum GRIA2 is higher in patients with methamphetamine-use disorder than in healthy controls. PMID: 27767084
- This study demonstrated that a significant decrease in the protein level of GluN2A in major depression disorder. PMID: 27661418
- both the intracellular C-terminal domain (CTD) and the loop region between the M1 and M2 helices move during activation and the CTD is detached from the membrane PMID: 27313205
- The results of this study suggest that neurons in hypothalamic hamartoma may bear Ca(2+) -permeable AMPA receptors(GluA2 ) due to dislocation of ADAR2 PMID: 28195308
- A transient positive feedback mechanism between AMPAR and stargazin has implications for information processing in the brain, because it should allow activity-dependent facilitation of excitatory synaptic transmission through a postsynaptic mechanism. PMID: 26744192
- The GluR2 subunit of the AMPA receptor is involved in cell migration and calcium signaling. PMID: 26311781
- RAB39B selectively regulates GluA2 trafficking to determine synaptic AMPAR composition PMID: 25784538
- GRIA2*CCC polymorphism is genetic risk marker for paranoid schizophrenia in Russians.Low risk genetic markers of paranoid schizophrenia were revealed: in Tatars-GRIA2*T/T (rs43025506) of GRIA2 gene and GRIA2*CCT in Russians. PMID: 25842862
- GRIA2 is a useful marker for distinguishing solitary fibrous tumour from most mimics PMID: 24456377
- a link between neurodegenerative processes and deficient RNA editing of the GluA2 Q/R site. PMID: 24679603
- Statistical analysis showed no association between migraine and the GRIA2 and GRIA4 polymorphisms investigated. PMID: 24512576
- analysis of changes in receptor kinetics with the R628E charge-inverting mutation in the "linker" region of alpha-amino-3-hydroxy-5-methyl-4-isoxazolepropionic acid (AMPA) receptor PMID: 24550387
- We show that excitatory cortical-patterned neurons derived from multiple human pluripotent stem cell lines exhibit native-like maturation changes in AMPAR composition such that there is an increase in the expression of GluA2(R) subunits. PMID: 24623784
- The data potentially suggest a lack of epistatic interaction between GRIA2 and GRIA4 variants regarding clinical outcomes in patients with major depressive disorder. PMID: 23613500
- The ionotrophic glutamate receptors AMPA2 and AMPA3 were decreased in hippocampus in patient with multiple sclerosis. PMID: 23595422
- ADAR2 expression level reflects editing activity at the GluA2 Q/R site; although the edited GluA2 pre-mRNA is readily spliced, the unedited GluA2 pre-mRNA is also spliced and transported to the cytoplasm when ADAR2 expression is low. PMID: 22366356
- Did not observed significant association between GRIA2 polymorphisms and clinical improvement in patients with Major depressive disorder.But rs4302506 and rs4403097 single nucleotide polymorphisms could be associated with age of onset of the disease. PMID: 22057216
- We demonstrated that the expression of GRIA2 among the differentially expressed genes provides better prognosis of patients with advanced serous papillary ovarian adenocarcinoma. PMID: 22644307
- The balance of expression of nerve growth factor (NGF) and that of its receptors shifts toward cell death mechanisms during the progression of Alzheimer disease. PMID: 21397006
- the GluR2 gene is embedded into an open chromatin configuration in glioma cells and expression of GluR2 is controlled by REST and Sp1 PMID: 21948504
- SNPs within GRIA2 may not be associated with the development and treatment outcomes in BD PMID: 22122651
- significant association GRIA2 polymorphisms was found with the diagnosis of schizophrenia. PMID: 22094384
- We conclude that polymorphisms in the GluR2 gene (GRIA2) are not a major contributory factor in the pathogenesis of ALS. PMID: 20409611
- Data show that CALM influences the cell surface level of the AMPA receptor subunit GluR2. PMID: 21221849
- Gain-of-function glutamate receptor interacting protein 1 variants alter GluA2 recycling and surface distribution in patients with autism PMID: 21383172
- Transsynaptic signaling mediated by the extracellular domain of GluR2 regulates the stability of presynaptic terminals. PMID: 21173224
- [review] The importance of mGlu2/3 glutamate receptors during normal central nervous system development is likely to play an important mechanistic role in the neurodevelopmental hypothesis of schizophrenia. PMID: 19933774
- Post-transcriptional editing of this subunit at the Q/R/N site controls calcium permeability PMID: 11860506
- role of interaction with N-ethylmaleimide-sensitive factor in regulation of AMPA receptors by brain-derived neurotrophic factor PMID: 12130635
- Low levels of GluR2 mRNA in motoneurons of ALS did not differ from the control group, implying that selective reduction of the GluR2 subunit cannot be a mechanism of AMPA receptor-mediated neurotoxicity in ALS PMID: 12694394
- the Q/R site of GluRs editing is regulated in a regional manner and the GluR2 Q/R site editing is critically regulated by ADAR2 in human brain PMID: 12859334
- GluR2, a subunit of a ligand-gated cation channel, is up-regulated in leiomyomata relative to myometrium by 15- to 30-fold at the protein and mRNA level and is localized in endothelial cells PMID: 14630051
- There is a defect in the editing of the mRNA encoding the GluR2 subunit of glutamate AMPA receptors in the spinal motor neurons of individuals affected by amyotrophic lateral sclerosis PMID: 14985749
- R/G editing status: the relative amount of edited GLUR2 mRNA was increased in epileptic hippocampi, whereas no changes were found in neocortical tissues. PMID: 15006707
- Control of GLUR2 translation was mediated by a sequence containing a 34-42 nucleotide imperfect GU repeat predicted to form secondary structure in vivo. This translation suppression domain is included in some rat and human GluR2 transcripts in vivo PMID: 15071096
- GluR2 was localized to the perikarya and proximal dendrites of BLA neurons; dense labeling was also present over the pyramidal cell layer of hippocampal subfields CA1 and CA3 PMID: 16045445
- Circumstance data have indicated that the GluR2 subunits dictate Ca2+/Zn2+ permeability of AMPA receptor channels and gate injurious Ca2+/Zn2+ signals in vulnerable neurons. PMID: 16215279
- Laser capture microdissection combined with quantitative PCR was used to examine the expression of AMPA (GRIA1-4) and NMDA (GRIN1, 2A and 2B) subunit mRNA levels in Layer II/III and Layer V pyramidal cells PMID: 17942280
- Of the three AMPA genes analyzed here, only GRIA3 seems to be involved in the pathogenesis of schizophrenia, but only in females. PMID: 18163426
- utilized reverse-transcription polymerase chain reaction and BbvI digestion to demonstrate that neural progenitor cells contain Q/R-unedited GluR2, and differentiated cells contain Q/R-edited GluR2 subunits PMID: 18403631
- the GluR4 subunit exhibits a different correlation between receptor activation and ligand-binding domain cleft closure than does GluR2 PMID: 19102704
- These findings indicate that the absence of the GluR2 subunit favours malignancy in gliomas PMID: 19558602
- This dimeric structure provides a mechanism for how the ATDs can drive receptor assembly and subtype-restricted composition. PMID: 19651138
顯示更多
收起更多
-
亞細胞定位:Cell membrane; Multi-pass membrane protein. Endoplasmic reticulum membrane; Multi-pass membrane protein. Cell junction, synapse, postsynaptic cell membrane; Multi-pass membrane protein. Cell junction, synapse, postsynaptic density membrane; Multi-pass membrane protein.
-
蛋白家族:Glutamate-gated ion channel (TC 1.A.10.1) family, GRIA2 subfamily
-
數據庫鏈接:
Most popular with customers
-
-
YWHAB Recombinant Monoclonal Antibody
Applications: ELISA, WB, IHC, IF, FC
Species Reactivity: Human, Mouse, Rat
-
Phospho-YAP1 (S127) Recombinant Monoclonal Antibody
Applications: ELISA, WB, IHC
Species Reactivity: Human
-
-
-
-
-